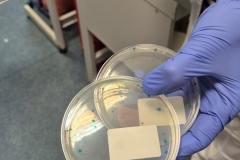
eurofins15

- (55) 646 06 30 Fax: (55) 646 06 31
- dyrektor@tech3.malbork.pl Napisz wiadomość
- Aleja Wojska Polskiego 502 82-200 Malbork
- Start
- Aktualności
- Plan lekcji
- Zastępstwa
- Matura
- Egzamin zawodowy
- Szkoła
- O szkole w mediach
- Lecia szkoły
- Sukcesy
- Sukcesy szkoły 2024/2025
- Sukcesy szkoły 2023/2024
- Sukcesy Szkoły 2022/2023
- Sukcesy Szkoły 2021/2022
- Sukcesy Szkoły 2020/2021
- Sukcesy Szkoły 2019/2020
- Sukcesy Szkoły 2018/2019
- Sukcesy Szkoły 2017/2018
- Sukcesy Szkoły 2016/2017
- Sukcesy Szkoły – 2015/2016
- Sukcesy Szkoły – 2014/2015
- Sukcesy Szkoły – 2013/2014
- Sukcesy Szkoły – 2012/2013
- Sukcesy Szkoły – 2011/2012
- Sukcesy Szkoły 1998 – 2010
- Kadra
- Standardy ochrony małoletnich w Technikum nr 3
- Klasy
- Kalendarz roku 2025/2026
- Zebrania z rodzicami 2025/2026
- Punktowy System Oceniania Zachowania
- Wymagania edukacyjne 2025/2026
- Biblioteka
- Beehive – szkolna gazetka w języku angielskim
- Absolwenci
- Zajęcia pozalekcyjne
- Ubezpieczenia uczniów
- Pomoc specjalistyczna 2025/2026
- Stypendia 2025/2026
- Innowacje
- Partnerzy szkoły
- Sala konferencyjno-bankietowa
- Procedura przyjmowania i rozpatrywania skarg i wniosków
- Oferty pracy
- Obowiązek informacyjny RODO
- Rekrutacja
- Galeria
- Dokumenty


Galeria – Rok szkolny 2025/2026
Home Galeria – Rok szkolny 2025/2026
- Rok szkolny 2025/2026 »
- 17-11-2025 wizyta w Eurofins